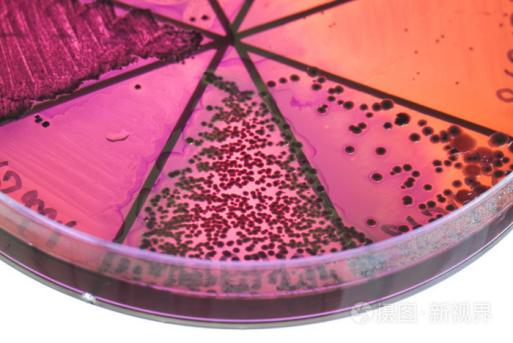
image.png

发布时间:2023-10-30 16:08:54 浏览次数:583次

案例2:给我一分信任,还您十分满意!
一、案例描述
8月酷热的空气中散发着一阵阵臭味,肥满的苍蝇争先恐后向着臭味深处寻找食物,蛋鸡养殖场东南角的草剁丛中已经隆起了一座小山丘。“诺,那就是今天刚捡出来的”!老李手指夹住他要熄灭的烟狠狠吸了两大口,往地上一扔,用他那破旧的胶鞋踩上去用力嗞了几下。吐出的烟冲散在让人窒息的空气中,笼罩着他紧锁的眉头不肯散去。看来,老李是真的急了。

两三个月前他养的鸡零零星星开始有一些精神萎靡不振,懒洋洋散落在鸡场的角落里打瞌睡。按他大半辈子养鸡的经验来看,这鸡恐怕是要生病了。于是老李像往常一样给他的鸡用上了一些中药制剂。如果不是没办法,他也不想用抗生素,因为他家的二娃以前身体不好总是生病,用了太多这东西了,有一次差点没有药可以用了,后来还是去了市里面的大医院才打了几针才把病情控制下来。虽然说不清到底哪里不好,但是他还是本能地觉得这玩意用多了就是不好。

半个月下来,他的鸡不见好转,接二连三出现死亡,这几天又开始增多了,要这样下去恐怕是要亏本。眼看着这不分白天黑夜养辛辛苦苦养的鸡正值下蛋的时候,还等着卖了这蛋好给准备要大学的孩子交学费,又出这么个差子,老李心里很不是滋味。干脆还是把抗生素用上去!按照往常的经验,用上去很快就会好了。于是按照经验老李把几种药一混,为了防止反弹,他特地每种都比上一次多加了一点,边加他边咕隆着:“要是一次不把它整干净,反起来要人命哟”!
果然“药到病除”,没几天病情控制住了,这才让老李怯生生地叹了一口气“哎!...”(真是不用不行哦,要是还养鸡怕是一辈子都离不了它咯)。虽然深知这药用多了不好,但不用恐怕会亏得裤衩儿都没了。

在我们见到老李的那刻,看得到他脸上的矛盾和中年人的焦虑与无奈。原来,他在这几个月的时间里已经反反复复用了好几次“狠方”了。因为每天零零星星的还是有不少鸡在死亡,所以他一直在用药。另一方面他又担心自己用药狠了出现耐药的情况,所以他还不断在各个厂家寻找秘方,希望能解决他的问题。每天除了起早贪黑地照顾他的鸡群,剩下的时间几乎都放在了给鸡找药这件事情上。但这一次不知道怎么了,以往也就持续个把月就解决了,这次咋就这么久,还越治越厉害了?!“听说你们是专家,研究噬菌体十几年了,这回好好帮帮我!”老李见到我们的时候嘴角露出了一丝笑容。也不是太热情,也许是方法试过太多完全失去了信心,也可能从来没用过噬菌体有一些怀疑。

在老李半信半疑下,我们的技术老师查看了整个养殖场的环境设施,仔细采集了各种样品,查看病鸡死鸡状态,进行初步临床检查,认真如实记录情况。完毕之后,给老李交代了需要注意和配合的地方。并给老李一句话:“您的事就是我们的事,您放心,噬菌体减抗替抗是我们最擅长,是我们能解决的问题我们会义无反顾帮您解决。”接下来就是等待实验室检测诊断结果。

经解剖观察与病理诊断,老李养殖场存在严重的细菌合并感染,且致病菌的耐药情况已经非常严重。经技术支持平台分离鉴定,病原学分析,毒力因子等分析,从庞大的噬菌体库中筛选匹配到专门能猎杀老李养殖场的病原菌的噬菌体,并进行可行性验证。经综合分析,专家团给老李养殖场的提出了科学的可行性综合方案。
二、之微健康管理方案
1、采用科学定制的噬菌体鸡尾酒复方进行疗程净化
2、持续环境监测,断绝感染源头
3、加强管理措施,避免持续交叉感染
三、效果反馈
老李在技术老师的指导下认真执行健康管理方案,第1天第2天鸡的死亡数量并没有下降,老李很是焦急,每天三次灵魂拷问“怎么还是这样?”“啥时候能好点?”在技术老师的耐心指导下,老李还是坚持做完整个周期,在第4天的时候,情况一下出现了反转,死亡率大幅下降,产蛋率开始上升,鸡的状态一天比一天好。老李眉头的乌云一天天散开,从刚开始不信任不以为然,到后来越来越有信心。经过又一轮采样检测,老李养殖场内的病原菌已经检测不到了。

一个周期下来,病原菌净化完成了,老李很是开心,至少整个周期内他没看到病情反复的情况,而是一天天在好转,他已经连续几个月没有这种心情了。为此他特地拿出了他珍藏了几年的老酒,因为我们他还特地炒了几个荤菜,酒后一开嗓唱了他挚爱的一首老歌。趁着醉意,他对我们说出了他的肺腑之言:“你们知道吗?这么多年,我真不想用药了!药那是越用越多,越用越贵!...”说罢夹起一块肉放进嘴里嚼得很香。我能理解,那一刻老李在做自己,这么多年他终于找到了内心的和谐。
接下来的几个月老李持续反馈鸡场情况稳定,我们的技术老师还是那句老话:“您给我一分信任,我还您十分满意!”
上一条:之微方案3天解决鹌鹑腹膜炎顽疾
下一条:之微方案降低鹅场病死率

服务热线(期待您的来电):

地址:湖北省武汉市江夏区郑店街道光谷南大健康产业园30号

邮箱:HBZW_Chenzaiwei@163.com
扫一扫关注我们
